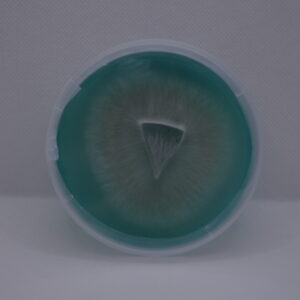

Easy Shroom’s Sterile Pre-Poured Grain Soak Agar Plates with Extra Parafilm
These pre-poured sterile agar plates are perfect for germinating fungal spores, cloning and storing unique specimens, and isolating and expanding mycelium cultures. Agar petri dishes are completely sterile to allow mycelium to grow rapidly without contamination. Each dish contains sterilized grain soak agar (GSA) dyed blue for easier inspection. GSA is our favorite nutrient medium to grow out clean gourmet and medicinal cultures really quickly because it is exactly what mushrooms love to eat: grains!
Pre-poured sterile agar plates are convenient and ready to use at home or for commercial mushroom cultivation. Our plates are poured and packaged in our sterile lab in front of a laminar flowhood. Each plate is individually wrapped and comes with an extra strip of parafilm. With our high-quality grain soak agar plates, you can expect consistent and reliable results for all your mycology experiments.
Available in packs of 5, 10, and 20 plates.
Grain Soak Agar Plate Specs:
🍄 Sterile Pre-Poured Grain Soak Agar (GSA) Plates
🍄 Poured & Packaged in Front of a Laminar Flowhood
🍄 Dyed Blue to Aid in Culture Inspection (Send us an email if you prefer other colors)
🍄 100mm x 15mm Petri Dishes
🍄 Individually Wrapped for Convenience and Sterility
🍄 BONUS 🍄 Pre-Cut Parafilm Strips for Sealing Each Plate
Working with agar is generally considered more advanced and requires a sterile work environment. While a flowhood is the preferred way to ensure sterility, a simple still air box (SAB) can be just as effective. You can make a still air box easily by simply drilling 2 arm holes in a large, clear tote. A SAB is a low-cost way to avoid contamination when working with agar.
Storage: For best results, use plates as soon as possible after delivery. Store unused plates upright at room temperature and away from direct sunlight. Storing in the fridge will extend shelf life but can lead to condensation on the lid which reduces visibility.
Culture Storage: Store colonized plates upright in the refrigerator.
Condensation: Condensation may occur due to rapid changes in temperature. This does not increase the risk of contamination since our agar plates are completely sterile, but it is an inconvenience that reduces visibility. If it is cold outside when plates are delivered, we recommend placing plates in the fridge for an hour or two before moving them to room temperature.
Guarantee: Easy Shroom takes extra care when packaging agar plates so you receive high quality GSA plates ready to use. Plates should arrive in excellent condition and are guaranteed contaminant-free upon arrival. If there are any problems whatsoever when you receive your plates, just send us an email with details and pictures and we will send replacements.